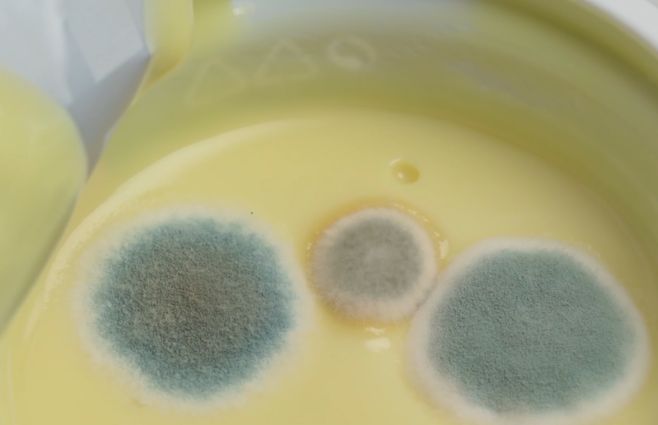
Inocuidad alimentaria ante las altas temperaturas en verano. IMM recibe denuncias.&nbsp;

La Intendencia de Montevideo (IMM) advierte a la población sobre los efectos nocivos para la salud de los alimentos que sufren el corte de la cadena de frío. En esta época de verano aumentan las intoxicaciones por estas causas.
Inocuidad de los alimentos en verano: IMM recibe denuncias por afectación en la cadena de frío
"A veces las personas terminan de hacer las compras de supermercado, salen a dar una vuelta, y las compras quedan en el auto, con las temperaturas altas", explican desde el Servicio de Regulación Alimentaria.
La inocuidad alimentaria es la garantía de que los alimentos no causarán daño a la salud del consumidor. Pero el verano es un factor de riesgo porque con las altas temperaturas crecen la mayoría de los microorganismos. Por eso es necesario realizar acciones para mantener la cadena de frío. Por ejemplo, en el supermercado, lo último que se retira de las góndolas para ir a la caja es lo que está en heladeras y cuando se traslada evitar las demoras.
"Lo que pasa a veces es que las personas terminan de hacer las compras de supermercado, salen a dar una vuelta, a levantar a los hijos de tal lugar, a hacer otro mandadito que tenían que hacer, y las compras quedan en el auto, con las temperaturas altas. Lo importante es que terminemos de hacer las compras y vayamos a nuestras casas, guardamos lo que va refrigerado", explicó Guzmán Reyes, director de Inspección y Tecnología del Servicio de Regulación Alimentaria (SRA).
Se realizó el segundo Congreso internacional de neurodivergencia
Reyes explicó que en verano hay un incremento de las notificaciones o denuncias por el estado de los alimentos y el no respeto de la cadena de frío.
"Lo que puede aumentar en verano son intoxicaciones, enfermedades transmitidas por alimentos (ETAS), porque el factor de riesgo es la temperatura", añadió.
Sobre las denuncias detalló que las más comunes son "por falta de higiene de locales, presencia de roedores, puede haber llegado también a veces algún objeto extraño en alimento. Nos ha llegado una colilla de cigarrillo adentro de una masa de pan".
El SRA de Montevideo recibe unas 2500 denuncias anuales aproximadamente y cuenta con 15 personas en el área inspectiva. Los alimentos frescos deben estar con temperatura por debajo de 7º y si son congelados menos 18 grados.
"Lo importante es verificar la temperatura del alimento, porque los equipos de frío muchas veces están funcionando bien, pero tienen sensor o termocúpula en la salida del frío, entonces te marca cuatro grados, pero de repente tenés una estiba de fiambres gigantes que tapa la circulación de frío, y el fiambre que está adelante no le está llegando bien la temperatura y está a 12º, 13ºC", añadió.
El contacto por denuncias es 950 3000 opción 4 o a través de la web www.montevideo.gub.uy.
Lo más visto
video
Dejá tu comentario